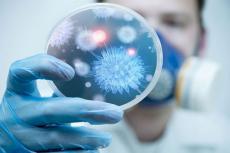

Шипинці відзначили 660-ту річницю з дня першої письмової згадки
02-07-2019, 17:44
У неділю, 30 червня, древні Шипинці відзначили 660-ту річницю з дня першої письмової згадки, яку залишив польський літописець Ян Длугош, згадавши у своїх записах землю під назвою «Шипинська». Так у середині 14 століття називали територію Північної Буковини, адміністративним центром якого було село Шипинці. Зібрані археологічні матеріали свідчать, що виникло це поселення десь у другій половині 13 століття. Тоді ця територія входила до Галицько-Волинського князівства.
Привітали кожну сільську родину і кожного шипинчанина староста Шипинецького старостинського округу Василь Нявчук, депутати Верховної Ради Іван Рибак та Василь Амельченко, міський голова Кіцманської об’єднаної територіальної громади Сергій Булега, виконуючий обов’язки голови райдержадміністрації Юрій Косар. Всі вони завітали в Шипинці не з порожніми руками, вручили нагороди, почесні грамоти та пам’ятні подарунки шипинчанам, які наполегливо трудяться на благо рідного села та сприяють його розквіту.